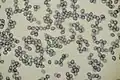
Sporen

Rossige melkzwam
| Rossige melkzwam | |||||||||||||||
|---|---|---|---|---|---|---|---|---|---|---|---|---|---|---|---|

| |||||||||||||||
| Taxonomische indeling | |||||||||||||||
| |||||||||||||||
| Soort | |||||||||||||||
| Lactarius rufus (Scop.) Fr. (1838) | |||||||||||||||
| Afbeeldingen op | |||||||||||||||
| Rossige melkzwam op | |||||||||||||||
| |||||||||||||||
De rossige melkzwam (Lactarius rufus, basioniem: Agaricus rufus) is een niet eetbare paddenstoel uit de familie Russulaceae. De paddenstoel wordt voornamelijk aangetroffen in de buurt van naaldbomen, zoals sparren, maar hij kan ook voorkomen nabij berken. Hij is te vinden van de late lente tot in de late herfst.
Beschrijving
Uiterlijke kenmerken
- Hoed
De paddenstoel heeft een gewelfde roodbruine hoed, die trechtervormig kan worden naarmate ze groter wordt. De soortaanduiding rufus (Latijn voor rossig) refereert aan de kleur van de paddenstoel. De hoed kan een diameter van 10 cm bereiken.
- Lamellen
De lamellen, die veelal duidelijk zichtbaar zijn door de trechtervorm van de hoed, zijn oranje, geel tot donkerbruin van kleur.
- Steel
De steel is 4 tot 8 cm lang en 1 tot 2 cm dik. De kleur is bleek roodbruin en het vlees is wit.
- Melksap
Het stroomt vrij overvloedig. Het is waterig wit, mild van smaak, maar laat een bittere nasmaak achter. Het heeft een harsachtige geur.
- Smaak en geur
Het vlees is wit. De smaak is scherp en brandend. Tijdens het drogen geeft het een sterke kruidige geur af.
- Sporenprint
De spore-afdruk is wit.
Microscopische kenmerken
De breed elliptische sporen zijn 6,8 tot 9,5 µm lang en 5,3 tot 7,4 µm breed. De Q-waarde (verhouding tussen lengte en breedte van de sporen) is 1,2 tot 1,4. Het sporenornament is tot 0,7 µm hoog en bestaat uit afzonderlijke wratten en ribben die in een netwerk bijna volledig met elkaar verbonden zijn. De basidia van 35 tot 42 µm lang en 8 tot 9 µm breed zijn cilindrisch tot clavaat en dragen gewoonlijk vier sterigma's.
De talrijke, 28 tot 42 µm lange en 7-9 µm brede cheilocystidia zijn spoelvormig tot clavaat en stomp aan de bovenkant, of gedeeltelijk verlengd tot een punt. De pleurocystidia zijn vergelijkbaar van vorm. Ze zijn min of meer cilindrisch tot clavaat of spoelvormig en sommige hebben een verlengde punt. Ze meten 25-60 × 6-10 µm en zijn niet erg talrijk.
De hoedhuid bestaat uit hyfen die evenwijdig en radiaal aan het hoedoppervlak liggen, die 2 tot 6 µm breed, cilindrisch van vorm en op sommige plaatsen onregelmatig met elkaar verweven zijn.
Verspreiding

De rossige melkzwam komt voor in Noord-Azië (Armenië, Siberië, Kamtsjatka, Japan, Korea), Noord-Amerika (Mexico, Verenigde Staten en Canada, vooral in het gebied van de Grote Meren), Groenland en Europa. In Europa komt de soort submeridiaan tot boreaal voor, wat wil zeggen dat het verspreidingsgebied zich uitstrekt van het noordelijke Middellandse Zeegebied tot in de noordelijke naaldbossen. In Zuid-Europa komt hij voor van Spanje tot Bulgarije, in West-Europa strekt het verspreidingsgebied zich uit van Frankrijk, via de Beneluxlanden en Engeland naar het noorden tot de Shetland-eilanden en in het oosten van Oekraïne via Wit-Rusland tot de Baltische staten. In het noorden is hij wijdverbreid in heel Fennoscandinavië. De soort komt in Midden-Europa zowel in de laaglanden als in de bergen voor. In de Zwitserse Centrale Alpen is hij te vinden op een hoogte van 2300 meter onder dennen.
In Nederland komt de rossige melkzwam zeer algemeen voor. Hij is niet bedreigd [1].
Foto's
-
 Zijaanzicht
Zijaanzicht -
 Lamellen met melksap
Lamellen met melksap -
 Groepje met habitat
Groepje met habitat -
Sporen
Sporen
Externe links
- Nomenclatuur in de Index Fungorum
- SoortenBank.nl - beschrijving en afbeeldingen